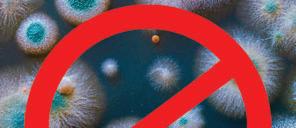

Pets, Vets & Shelters

Protecting People and Pets
The Safe Place Commpany™ helps the Pet Care industry keep patients and personnel safe, health and ProTech-ed.

In the past 10 years, emergences of fatal infectious diseases have originated in sheltered populations. Novel potential pathogens such as canine circoviruses, bocavirus, kobuvirus, and sapovirus, as well as feline noroviruses, have all been discovered in sheltered animals. Other diseases include respiratory, neurologic, and systemic streptococcal infections (dog and cat); canine influenza; hemorrhagic respiratory Escherichia coli (dog) infection; and virulent systemic feline calicivirus infection.
Sheltered animals are faced with increased personal health risks, support infectious disease transmission to the community pet population, and have relatively unguarded access to humans. In a herd health situation such as a shelter, there is merit in establishing an etiologic diagnosis both for disease management and for recognition of potential zoonoses. Stressed animals support higher infection and
shedding rates of potential pathogens such as feline enteric coronavirus, canine enteric coronavirus (CECoV), feline herpesvirus, and feline calicivirus.
The relatively unpredictable crowding and transience of a shelter population can support an explosive expansion of viral or bacterial organisms with periodic host movement or other pathogen population bottlenecks, a situation that could theoretically support the selection of pathogen variants.
PronTech™ is a patented antimicrobial that has been used in commercial animal settings for decades, including dairy and feed lots, and in recent years has found increasing public applications such as in hospitals and schools. It was recently tested and given FDA approval for the effective elimination and long-lasting prevention (more than 24 hours between application) of the human Covid-19 virus.



The Safe Place Company™ has strategically adapted the concept of HACCP for several types of environments in order to excel at each one of the operation’s critical control points where diseases can be transmitted. HACCP with the broadbased application of the PRONTECH TECHNOLOGY can prevent and eliminate a broad spectrum of harmful pathogens from all surfaces and can be effectively used in any environment.
Technology Starter Kits Products


Protocols

SPECIAL COVID-19 EDITION
1
What is HACCP?
Hazard Analysis and Critical Control Points (HACCP) is a 1996 FDA protocol to mitigate biological, chemical and physical hazards for the safety and quality of food preparation by identifying unsafe links in the food processing chain. HACCP assures maximum efficacy and is preferred by professionals around the world.
HACCP is based on seven basic principles:
1. Conduct a hazard analysis
2. Determine critical control points
3. Establish critical limits
4. Establish monitoring limits
5. Establish corrective actions
6. Establish verification procedures
7. Establish effective record keeping procedures
The Safe Place Company™ has applied HACCP to new CDC guidelines for in-room classes to help the pet care industry:
1. Minimize diseases caused by pathogens which can be transmitted from one individual human or animal to another.
2. Minimize the risk of transmission by following guidelines provided by UPI.
3. Follow up a Pathogen Elimination Control Plan in order to avoid the spread of diseases.
4. Follow up a regular disinfection program in order to minimize the risk of contamination.

5. Understand the importance of using a registered product for disinfection.
Common Endemic Diseases in Animal Shelters and Boarding Environments include Feline Herpesvirus, Canine Distemper Virus, Canine Influenza, Feline Calicivirus, Feline and Canine Parvoviruses, Feline Infectious Peritonitis, and Hemolytic Streptococci just to name a few.

And while The Safe Place Company™ is intensely focused on the elimination and protection from Covid-19, we are addressing a broad range of biological hazards that can be divided into three categories: microorganisms, parasites and prions. It has been reported that microorganisms are the principal sources of food borne diseases.
Parasites
Cysticercoid, Tenia spp., trematodes, nematodes, cestodes, Trichinella spp., Echinococcus spp., Cryptococcus spp. and Anisakis spp. are commonly isolated parasites from foods. Raw meat and fish are the riskiest foods for parasite infections.
Prions
Prions are considered as causative agent of “Bovine Spongiform Encephalitis” (BSE). They are resistant to heat treatments and mainly isolated.
Viruses
Hepatitis A, poliovirus, rotavirus, orthomyxovirus, influenza, astrovirus and Norwalk viruses are transmitted to man by foods, drinking water and air. Contamination occurs through faucal oral route.
Molds
Molds represent health hazards because of their toxic metabolites called mycotoxins. Mycotoxins may be produced in some plants in the field or during drying and storage under improper conditions.
Algae
Some types of algae such as Cyanobacteria (blue green algae) and Pyrrophyta (dinoflagellates) produce toxic compounds for compounds for human beings and animals. Poisoning occur after consumption of some seafood fed with these toxic algae.
Bacteria
Food borne diseases caused by performed toxins are referred to as food poisoning (intoxications), whereas food disorders cased by bacterial growth or endotoxin production in the body after ingestion are call food infections. It is very important to understand that bacteria can survive on any surface and remain there until the conditions are right to develop into diseases. They do not necessarily have to be located in food. Bacteria can be transmitted by any human or animal bodily fluids to any surface and to other humans or animals.
PronTech™ ensures all touch points are pathogen free
2
Medical Facilities
SAFE PLACE PROTOCOLS PET CARE INDUSTRY
Commerical s
Veterinary, Boarding & Shelter Protocols
Health Care
• Schedule entryway, waiting room and common-area sanitization to ensure continuous coverage throughout facilitiy hours.
Wheelchairs facility
• Spray walls, floors, handrails, counter tops and HVAC vents with PronTech™, allowing mist to dry evaporatively.

• Place SaniMats on entry area walking paths; mats may be sprayed as often as every four hours for added protection.
• Sanitize all exam room surfaces between each animal.

• Fog a solution of PronTech™ in facility interior to provide envrionmental disinfection. Air curculation tools are available for this time of application.
Wheelchairs facility facilitie building
tuurriizzeer r – A Annttiibbaacctteerriiaal l
9 99 9 9 99999% % E Effffeeccttiivve e K Kiilll l a annd d P Prreevveennttiioon n Aggaaiinnsst t B Baacctteerriia a- F Fuunnggi i- V Viirruussees s- A Allggaaee, , I Inncclluuddiinng g M MRRSSA A – F Flluu//HH11NN1 1- C COOVVIIDD--119 9
• Place TopSani™ Hand Sanitizer Stations at intervals throughout the facility with signage indicating that it remains effective on skins and fur for several hours as people and animals travel through the entryway and between rooms.

• Treat and repeat after building closing process has been completed.
Special Considerations
4 Hour Glove Like Protection –
Delivers at 99.999% Kill Rate
• Do not fog PronTech™ solution directly onto electrical equipment as it could intervere with proper function.
Penetrates through water, hand dirt, and skin oil
Non-alcohol , Non-chlorine based
FDA Approved
• HVAC vents should be cleaned with portable vacuum equipment as needed prior to fogging.
• Mop water with added PronTech™ must be changed when the mop head is not clearly visible through cloudy water.
Topsani Liquid d Public c Health h Hand d Disinfectant t
Lasting g Anti-Bacterial l Protection n
*Available e i in: : 2o z, , 8o z, , 32o z *
HEALTH CARE NEWS
fur and
3 P PrroonnTTeecchhTTM M L Liiqquuiid d P Puubblliic c H Heeaalltth h D Diissiinnffeeccttaannt t C Coonncceennttrraatte e o or r P Prree--MMiixxeed d * *AAvvaaiillaabblle e i in n 1 1, , 5 5, , 5 555, , 2 2775 5 G Gaalllloon n C Coonnttaaiinneerrss* * H Haannd d S Saanniittiizzeer r – M Mooiisst
1
H EALTH CARE NEWS
An intensively housed environment, like a shelter, can contribute to the emergence of novel pathogens, to novel hosts targeted by a pathogen, or to altered virulence.

[1] Introduction to host: Crowding; Increased contact; Mixed species; Re-activation of latent infection; Host susceptibility (unvaccinated/naive host); Extended transportation

[5] Introduction to new host
[4b] Envrionmental stability: Polymicrobial infections; Chemical and physical alterations of ecosystem (cleaning practices); Personnel, families

�reate saniti�er stations �or customers and sta�� ali�e to disin�ect t�eir �ands as t�e� come and �o �rom buildin�s� common areas and classrooms� �ro�ide eas� access to disposable mas�s and �lo�es so t�at no indi�idual �ill �a�e to �o �it�out� �eac� and monitor �requent and proper use o� saniti�ers and ��� items�


[2] Establishment within host: Stress-induced immunosuppression; Age-related immune compromise; Polymicrobial infections; Microbiome alterations (e.g., food change/fasting)
[3] Alteration within host: Stress-induced immunosuppression; Antibiotic use affects evolution of pathogens (overuse or indiscriminate use); Vaccine-driven evolution of pathogens; Polymicrobial infections (recomination, gene trading)
[4a] Stability within host (clearance, persistence, latency): Stress-induced immunosuppression; Microbiome alterations (e.g., stress, change in nutrition, antibiotic use); Immune status; Genetic susceptibility (breed)
Waiting Rooms


�ommon areas include �all�a�s and entr��a�s� court�ards and and suppl� closets� �aniti�in����� stations s�ould be placed at entr ances and sur�ace disin�ection sc�eduled at re�ular inter�als to meet room�use demands�
�re cleaned to pro�ide a sa�e and �orr���ree en�ironment �or animals� emplo�ees� and �endors to a�oid cross contamination� �omplete room cleanin� and disin�ectin� is a priorit� and s�ould be done dail� and ni��tl�� ��is means dail� saniti�in� sur�aces and ob�ects t�at are touc�ed o�ten� suc� as s�el�es� countertops� door�nobs� to name a �e��
4
Frequently touched surfaces should be cleaned and disinfected at least once a day (i.e., before or after ), and more frequently when possible. shared by animals, staff and pet owners for any frequently touched surfaces.
























H EALTH CARE N E W S HEALTH CARE N E W S
r r 5 THE SAFE PLACE C O M P A N Y THE SAFE PLACE C O M P A N Y SHOW YOUR CUSTOMERS THEY ARE PRONTECH-ED THE SAFE PLACE O M P N Y POSTERS 5.5”x8.5”, 8.5”x11” 11”x17”, 20”x30” THE SAFE PLACE
PRONTECH™ TECHNOLOGY













P AGE 7 HEALTH CARE NEWS
UPI have WOOD GLASS FABRIC CARPET 6 99.99% Effective
and Prevention gainst Bacteria - Fungi - Viruses - Algae,
– Flu/H1N1 – COVID-19 P PrroonnTTeecchhTTM M L Liiqquuiid d P Puubblliic c H Heeaalltth h D Diissiinnffeeccttaannt t C Coonncceennttrraatte e o or r P Prree--MMiixxeed d * *AAvvaaiillaabblle e i in n 1 1, , 5 5, , 5 555, , 2 2775 5 G Gaalllloon n C Coonnttaaiinneerrss* * H Haannd d S Saanniittiizzeer r – M Mooiissttuurriizzeer r – A Annttiibbaacctteerriiaal l 9 99 9 9 99999% % E Effffeeccttiivve e K Kiilll l a annd d P Prreevveennttiioon n Aggaaiinnsst t B Baacctteerriia a- F Fuunnggi i- V Viirruussees s- A Allggaaee, , I Inncclluuddiinng g M MRRSSA A – F Flluu//HH11NN1 1- C COOVVIIDD--119 9
Topsani Liquid d Public c Health h Hand d Disinfectant t Lasting g Anti-Bacterial l Protection n *Available e i in: : 2o z, , 8o z, , 32o z * 1
all surfaces
Commercial PronTech
Kill
Including MRSA
4 Hour Glove Like Protection –Delivers at 99.999% Kill Rate Penetrates through water, hand dirt, and skin oil Non-alcohol , Non-chlorine based FDA Approved
for human/pets Penetrates
Will
irritate/dry
Effective
EPA
H EALTH CARE NEWS
OTHER MARKET APPLICATIONS on-alcohol non-chlorine basedDries in 10-30 seconds, Safe
water – oil - dirt
not
the skin
for long lasting kill and protection -
/FDA Approved for 6 hours all surfaces Fabric tested 99.99% effectiveness
PronTech™
such as examination rooms, lobbies, guest rooms, taxibusses food service and dining rooms restrooms,and . Many of these areas pose a common threat for H1N1, MRSA and Covid 19 and other viruses due to the shared space.













PronTech™ Benefits and Advantages

Features and Benefits
walls, ,
, examination rooms,
, examination
SPECIAL COVID-19 EDITION PAGE 8 C Commercial H EALTH CARE NEWS 7
pH Range (3-11)
PRONTECH VERSUS OTHER DISINFECTANTS

OTHER MARKET APPLICATIONS
99.99% Effective Kill and Prevention gainst
Bacteria - Fungi - Viruses - Algae, Including MRSA – Flu/H1N1 – COVID-19
on-alcohol non-chlorine basedDries in 10-30 seconds, Safe for human/pets
Penetrates water – oil - dirt
Will not irritate/dry the skin
Effective for long lasting kill and protection -
EPA /FDA Approved for 6 hours all surfaces
Fabric tested 99.99% effectiveness
4 Hour Glove Like Protection –
at 99.999% Kill Rate
Penetrates through water, hand dirt, and skin oil
Non-alcohol , Non-chlorine based
Approved

Does Not Work in that Range
Does Not Work in that Range
Does Not Work in that Range
Does Not Work in that Range Works in that Range!
P PrroonnTTeecchhTTM M L Liiqquuiid d P Puubblliic c H Heeaalltth h D Diissiinnffeeccttaannt t C Coonncceennttrraatte e o or r P Prree--MMiixxeed d * *AAvvaaiillaabblle e i in n 1 1, , 5 5, , 5 555, , 2 2775 5 G Gaalllloon n C Coonnttaaiinneerrss* * H Haannd d S Saanniittiizzeer r – M Mooiissttuurriizzeer r – A Annttiibbaacctteerriiaal l 9 999..999999% % E Effffeeccttiivve e K Kiilll l a annd d P Prreevveennttiioon n Aggaaiinnsst t B Baacctteerriia a- F Fuunnggi i- V Viirruussees s- A Allggaaee, , I Inncclluuddiinng g M MRRSSA A – F Flluu//HH11NN1 1- C COOVVIIDD--119 9
Delivers
FDA
Topsani Liquid d Public c Health h Hand d Disinfectant t Lasting g Anti-Bacterial l Protection n
e i in: : 2o z, , 8o z, , 32o z
1
*Available
*
H EALTH CARE NEWS
Comparison Glutaraldehyde Phenolics (single or multiple) Quaternary Ammonium Formaldehydes PRONTECH™ Toxicity I-IV II I-II II I-II IV Fogging in Human Presence No No Sometimes No Yes Irritability Highly Irritant Highly Irritant Highly Irritant Highly Irritant Slightly Irritant Deodorizing Not Good Deodorizer Good Deodorizer Not Good Deodorizer Not Good Deodorizer Very Good Deodorizer Tensoactive Capacity Up To 54% No No No No Yes Corrosiveness Highly Corrosive Highly Corrosive Some Moderately Corrosive Highly Corrosive Very Low Corrosiveness Hard Water Effectiveness (up to 800 ppm CaCO3 Effective Effective Not Effective Effective Effective Compatibility with Anionic Substances Yes Yes No Yes No Compatibility with Non-Ionic Substances (1-1.5) Yes Yes Yes Yes Yes Compatibility with Cationic Substances No No Yes Yes Yes Effecive Against Fungi (ex. Aspergillus) No Yes Some are Effective Yes Yes Effective against Viruses Yes Some are Effective Some are Effective Yes Yes Effective against Gram (+) Bacteria Yes Yes Yes Yes Yes Affective against Gram (-) Bacteria Yes Yes No Yes Yes Biodegradable Yes No Some are Biodegradable Yes Yes Residual Action Slight Residual Action Good Residual Action Limited Residual Action Low Residual Action Good Residual Action Organic Matter Slight to Moderate Effectiveness Effective in Presence of OM Low Effectiveness in Presence of OM Low Effectiveness in Presence of OM Effective in Presence of OM
8
PRONTECH APPLICATION GUIDE


OTHER MARKET APPLICATIONS
Destroys 99.99% all single cell microorganisms ON CONTACT!
Provides 24-Hour Protection!
99.99% Effective Kill and Prevention gainst
Bacteria - Fungi - Viruses - Algae, Including MRSA – Flu/H1N1 – COVID-19
on-alcohol non-chlorine basedDries in 10-30 seconds, Safe for human/pets
Penetrates water – oil - dirt
Will not irritate/dry the skin
Effective for long lasting kill and protection -
EPA /FDA Approved for 6 hours all surfaces
Fabric tested 99.99% effectiveness
PRONTECH™ DILUTION TABLE
Preparing solutions is made easy with the provided measuring scoop, which holds 3.8 grams of PronTech™ (i.e., one “dose”) for mixing volumes of solution quickly and accurately. Add PronTech™ to water (do not add water to PronTech™ as it will foam up); PronTech™ dissolves rapidly in hot or cold water, and remains stable in a closed container.
9
PrroonnTTeecchhTTM M L Liiqquuiid d P Puubblliic c H Heeaalltth h D Diissiinnffeeccttaannt t C Coonncceennttrraatte e o or r P Prree--MMiixxeed d
*AAv
ai
laabblle e i in n 1 1, , 5 5, , 5 555, , 2
G
* H Haannd d S Saanniittiizzeer r – M Mooiissttuurriizzeer r – A Annttiibbaacctteerriiaal l 9 999..999999% % E Effffeeccttiivve e K Kiilll l a annd d P Prreevveennttiioon n Aggaaiinnsst t B Baacctteerriia a- F Fuunnggi i- V Viirruussees s- A Allggaaee, , I Inncclluuddiinng g M MRRSSA A – F Flluu//HH11NN1 1- C COOVVIIDD--119 9 4 Hour Glove Like Protection –Delivers at 99.999% Kill Rate Penetrates through water, hand dirt, and skin oil Non-alcohol , Non-chlorine based FDA Approved Topsani Liquid d Public c Health h Hand d Disinfectant t Lasting g Anti-Bacterial l Protection n *Available e i in: : 2o z, , 8o z, , 32o z * 1
P
*
va
il
2775 5
Gaalllloon n C Coonnttaaiinneerrss*
H EALTH CARE NEWS
USE DILUTION APPLICATION Disinfection of containers 400 ppm (1 g/L of water) Apply solutions in direct contact, dry perfectly Disinfection of coool rooms and refrigerators 800 ppm (2 g/L of water) Apply by aspersion getting a perfect coverage of floors and walls Envrionmental disinfection 800 ppm (2 g/L of water) Aspersion Disinfection of walls and floors 400 ppm (1 g/L of water) Direct to the surface Disinfection of hands and gloves 400 ppm (1 g/L of water) Immersion Disinfection of work clothes 400 ppm (1 g/L of water) Direct aspersion Disinfection of vehicles for transportation 800 ppm (2 g/L of water) Direct aspersion YIELD PER POUND OF PRONTECH™ 1600 PPM 30 GALLONS 800 PPM 60 GALLONS 400 PPM 120 GALLONS 200 PPM 241 GALLONS 100 PPM 482 GALLONS ADD 1 DOSE (3.8g) OF PRONTECH™ TO: 1 QT. WATER FOR 1600 PPM 2 QTS. WATER FOR 800 PPM 1 GAL. WATER FOR 400 PPM 2 GALS. WATER FOR 200 PPM 4 GALS. WATER FOR 100 PPM
PRONTECH TECHNOLOGY OFFERINGS











on-alcohol non-chlorine basedDries in 10-30 seconds, Safe for










































Penetrates water – oil - dirt
























Will not irritate/dry the skin
Effective for long lasting kill and protection -



























/FDA Approved for 6 hours all surfaces Fabric
Penetrates through water, hand dirt, and skin oil
10 200 GRAM STARTER KITS 500 GRAM STARTER KITS 1,000 GRAM STARTER KITS 99.99% Effective Kill and Prevention gainst Bacteria - Fungi - Viruses - Algae, Including MRSA – Flu/H1N1 – COVID-19 P PrroonnTTeecchhTTM M L Liiqquuiid d P Puubblliic c H Heeaalltth h D Di i i i f t n nt t C Co o a atte e o o i ixxeed d * * e i in 2 2 C H Haannd d S Saanniittiizzeer r – M Mooiissttuurriizzeer r – A Annttiibbaacctteerriiaal l 9 999..999999% % E Effffeeccttiivve e K Kiilll l a annd d P Prreevveennttiioon n Aggaaiinnsst t B Baacctteerriia a- F Fuunnggi i- V Viirruussees s- A Allggaaee, , I Inncclluuddiinng g M MRRSSA A – / 1- C C 4 Hour Glove Like Protection Delivers at 99.999%
Kill Rate
Liquid d Public c Health h Hand d Disinfectant t
g Anti-Bacterial l Protection n
e i in: : 2o z, , 8o z, , 32o z * 1
Non-alcohol , Non-chlorine based FDA Approved Topsani
Lasting
*Available
OTHER MARKET APPLICATIONS
human/pets
tested
effectiveness H EALTH CARE NEWS
EPA
99.99%
200 GRAM SINGLE UNIT 500 GRAM SINGLE UNIT 1,000 GRAM SINGLE UNIT 55 GALLON KIT 55 GALLON KIT 55 GALLON KIT 2.5 GALLON KIT 2.5 GALLON KIT 2.5 GALLON KIT 4 QTY 4 QTY 4 QTY 1 QTY 1 QTY 1 QTY 55 GALLON KIT + FOGGER 55 GALLON KIT + FOGGER 55 GALLON KIT + FOGGER 200 GRAM 24 UNITS 500 GRAM 24 UNITS 1,000 GRAM 8 UNITS 55 GALLON KIT 55 GALLON KIT 55 GALLON KIT 2.5 GALLON KIT 2.5 GALLON KIT 2.5 GALLON KIT +1 200 GRAM UNIT PRONTECH +1 500 GRAM UNIT PRONTECH +1 1,000 GRAM UNIT PRONTECH +1 200 GRAM UNIT PRONTECH +1 500 GRAM UNIT PRONTECH +1 1,000 GRAM UNIT PRONTECH +1 200 GRAM UNIT PRONTECH +1 500 GRAM UNIT PRONTECH +1 1,000 GRAM UNIT PRONTECH +1 FOGGER 55 GALLON KIT + FOGGER 55 GALLON KIT + FOGGER 55 GALLON KIT + FOGGER
MARKET APPLICATIONS
99.99% Effective Kill and Prevention gainst
Bacteria - Fungi - Viruses - Algae, Including MRSA – Flu/H1N1 – COVID-19
99.99% Effective Kill-Rate and Prevention
on-alcohol non-chlorine basedDries in 10-30 seconds, Safe for human/pets
Penetrates water – oil - dirt
• PRONTECH a unique virucide ,bactericide, fungicide, and algaecide.
Will not irritate/dry the skin
Effective for long lasting kill and protection -
• Safe to use on any surface, Non-carcinogenic
EPA /FDA Approved for 6 hours all surfaces
• PRONTECH has been used in more than a dozen industrial application for over 30 years



Fabric tested 99.99% effectiveness
• Easy to mix, 100% soluble in regular tap water
• Eco-Friendly,100% biodegradable
• Non-alcohol, Non-chlorine
• No residue, Eliminates odors
• Proven effective against the Live Human Coronavirus
• Treats, Controls and Prevents a broad spectrum of pathogens
• Kills on contact, Proven effective for at least 24 hours
• Can be used as a laundry additive to protect textiles form disease transfer
• Broad PH tolerance range is 3-11
• Wide temperature tolerance from below freezing to 131°F.
• Economical when mixed on site with regular tap water, costs less than $3.00 per gallon.
4 Hour Glove Like Protection –
Delivers at 99.999% Kill Rate
Penetrates through water, hand dirt, and skin oil
Non-alcohol , Non-chlorine based
FDA Approved
• Four Hour Glove-Like Protection, efficacy lasts up to 24 hours
• Penetrates through water, hand dirt and skin oil
• Non-alcohol, Non-chlorine based, Dires in 10-30 seconds
• FDA Approved
Topsani Liquid d Public c Health h Hand d Disinfectant t Lasting g Anti-Bacterial l Protection n


*Available e in: : 2o z, , 8o z, , 32o z *

11
P PrroonnTTeecchhTTM M L Liiqquuiid d P Puubblliic c H Heeaalltth h D Diissiinnffeeccttaannt t C Coonncceennttrraatte e o or r P Prree--MMiixxeed d * *AAvvaaiillaabblle e i in n 1 1, , 5 5, , 5 555, , 2 2775 5 G Gaalllloon n C Coonnttaaiinneerrss* * r r –– A Annttiibbaacctteerriia
d d P Prreev
all
veennttiioon n
PronTech™ Liquid Disinfectant
Topsani Gel Public Health Hand Disinfectant
Kill-Rate and Prevention Hand Sanitizer | Moisturizers | Antibacterial Available in 2oz, 8oz, 32oz Containters
99.999% Effective
OTHER MARKET APPLICATIONS

COMMERCIAL
99.99% Effective Kill and Prevention gainst Bacteria - Fungi - Viruses - Algae, Including MRSA – Flu/H1N1 – COVID-19

on-alcohol non-chlorine basedDries in 10-30 seconds,
Penetrates water – oil - dirt
Will not irritate/dry the skin
Effective for long lasting kill and protection -

EPA /FDA Approved for 6 hours all surfaces

Fabric tested 99.99% effectiveness
4 Hour Glove Like Protection –
Delivers at 99.999% Kill Rate
Penetrates through water, hand dirt, and skin oil
Non-alcohol , Non-chlorine based
SCHOOLS AND TEXTILES AND VETERINARY


Keeps animal shelters and veterinary clinics safe by penetrating all surfaces of these locations with a product safe for both people and animals.




HEALTH CARE NEWS
PrroonnTTeecchhTTM M L Liiqquuiid d P
bl
ic c H
ea
D
C Coonncceennttrraatte e
P
e-
*AAvvaai
n
G
gaaiinnsst t B Baacctteerriia a- F Fuunnggi i- V Viirruussees s- A Allggaaee, , I Inncclluuddiinng g M MRRSSA A – F Flluu//HH11NN1 1- C COOVVIIDD--119 9
P
Puub
li
He
alltth h
Diissiinnffeeccttaannt t
o or r
Prre
-MMiixxeed d *
illaabblle e i in
1 1, , 5 5, , 5 555, , 2 2775 5
Gaalllloon n C Coonnttaaiinneerrss* * H Haannd d S Saanniittiizzeer r – M Mooiissttuurriizzeer r – A Annttiibbaacctteerriiaal l 9 999..999999% % E Effffeeccttiivve e K Kiilll l a annd d P Prreevveennttiioon n Ag
FDA
Topsani Liquid d Public c Health h Hand d Disinfectant t Lasting g Anti-Bacterial l Protection n
e i in: : 2o z, , 8o z, , 32o z * 1
Approved
*Available
Safe for human/pets
H EALTH CARE NEWS

The Safe Place Company™ 111 2nd Ave. NE, Suite 537 St. Petersburg, FL 33701 USA (727) 685-0515 www.thesafeplacecompany.com info@safeplacecompany.com 13